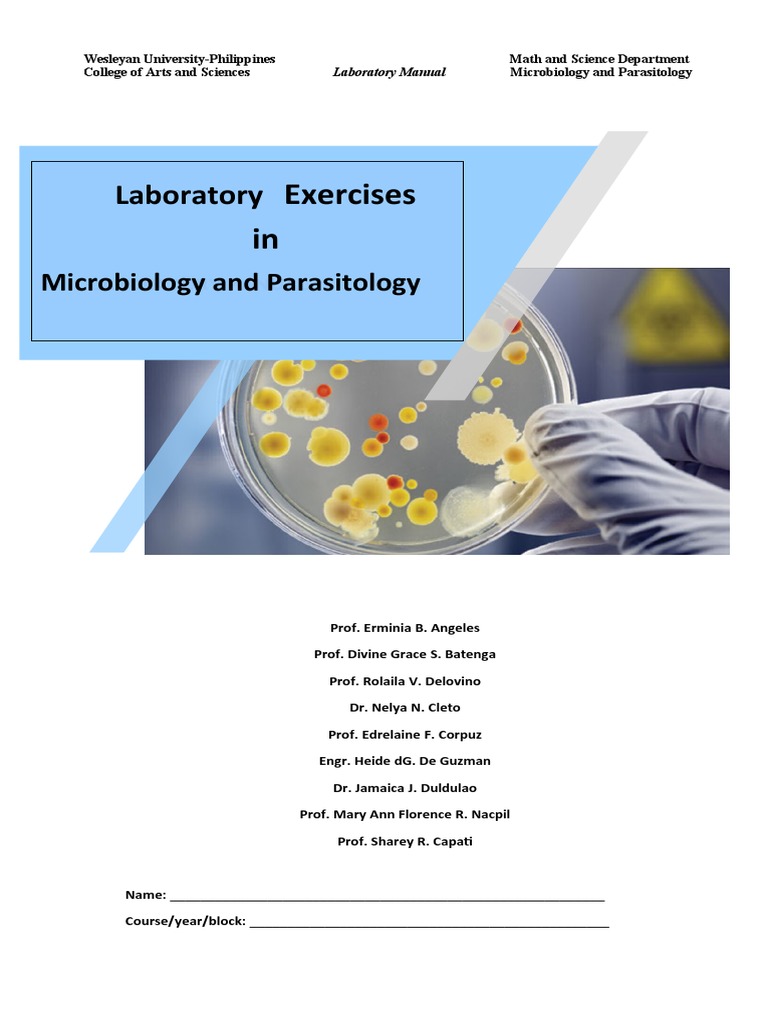
Micropara Lab Manual Summer 2021 2022 | PDF | Microscope | Laboratories

Step back in time with our remarkable vintage lab report template micro para prelim exams - micropara for nursing collection featuring extensive collections of nostalgic images. featuring nostalgic examples of photography, images, and pictures. ideal for nostalgic and classic themes. Each lab report template micro para prelim exams - micropara for nursing image is carefully selected for superior visual impact and professional quality. Suitable for various applications including web design, social media, personal projects, and digital content creation All lab report template micro para prelim exams - micropara for nursing images are available in high resolution with professional-grade quality, optimized for both digital and print applications, and include comprehensive metadata for easy organization and usage. Explore the versatility of our lab report template micro para prelim exams - micropara for nursing collection for various creative and professional projects. The lab report template micro para prelim exams - micropara for nursing collection represents years of careful curation and professional standards. Reliable customer support ensures smooth experience throughout the lab report template micro para prelim exams - micropara for nursing selection process. Advanced search capabilities make finding the perfect lab report template micro para prelim exams - micropara for nursing image effortless and efficient.






![Free Printable Lab Report Templates [PDF, Word]](https://www.typecalendar.com/wp-content/uploads/2023/05/Formal-Lab-Report-PDF-Example.jpg?gid=520)















































![Free Printable Lab Report Templates [PDF, Word]](https://www.typecalendar.com/wp-content/uploads/2023/05/Lab-Report-1200x675.jpg)

![Free Printable Lab Report Templates [PDF, Word]](https://www.typecalendar.com/wp-content/uploads/2023/05/Printable-Lab-Report-Example-scaled.jpg)






![Free Printable Lab Report Templates [PDF, Word]](https://www.typecalendar.com/wp-content/uploads/2023/05/Sample-Lab-Report-Template.jpg)


![Free Printable Lab Report Templates [PDF, Word]](https://www.typecalendar.com/wp-content/uploads/2023/05/Lab-Report-Word-Format-Example.jpg)


















































